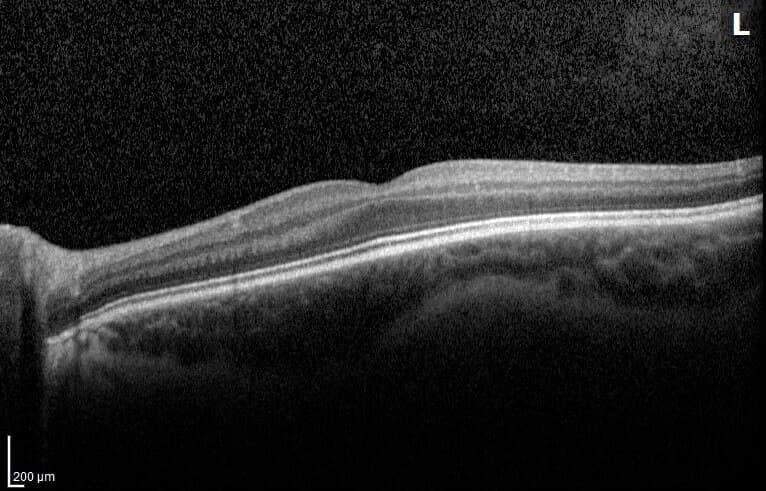
Tomografía de coherencia óptica de mácula

Lentes correctores
Anteojos
La alternativa más utilizada para corregir defectos refractivos y adaptar la graduación según las necesidades visuales del paciente.
Esta página reúne las principales patologías oculares y las opciones terapéuticas descritas en el documento del doctor, organizadas para que resulten más comprensibles para pacientes y familias.
Escribe una palabra clave y el sitio abrirá las categorías y temas relacionados. Funciona aunque no escribas las tildes.
Las categorías y los temas relacionados se abrirán automáticamente cuando haya coincidencias.
Abre solo el tema que necesitas revisar. La información queda completa, pero más ordenada para leer sin tener que bajar indefinidamente por la página.
Miopía, hipermetropía, astigmatismo y presbicia tienen causas y comportamientos distintos. Cada una requiere una evaluación precisa antes de definir corrección óptica o cirugía.
Patología
Defecto refractivo en el que los objetos cercanos se ven con mayor claridad y los lejanos se perciben borrosos.
Ver másOcultar detalleSuele relacionarse con una longitud ocular mayor o una curvatura excesiva de la córnea, lo que hace que la luz enfoque delante de la retina.
Patología
Defecto visual en el que los objetos cercanos se ven borrosos y los lejanos pueden apreciarse con mayor claridad.
Ver másOcultar detalleOcurre cuando la imagen se enfoca detrás de la retina y puede presentarse a distintas edades.
Patología
Alteración producida por una curvatura irregular de la córnea o del cristalino.
Ver másOcultar detallePuede causar visión borrosa o distorsionada, fatiga visual y dificultad para ver con nitidez en distintas distancias.
Patología
Condición asociada a la edad que afecta la capacidad de enfocar objetos cercanos.
Ver másOcultar detalleSuele aparecer entre los 40 y 45 años y progresa de manera gradual por la pérdida de flexibilidad del cristalino.
Patología
Pérdida de transparencia del cristalino, la lente natural del ojo, que puede reducir de forma importante la visión.
Ver másOcultar detalleEs más frecuente con la edad, aunque también puede presentarse en niños o tras traumatismos oculares.
El documento del doctor incluye distintas alternativas para tratar los vicios de refracción. La mejor elección depende de la edad, la graduación, la córnea, el cristalino y las expectativas visuales.
Lentes correctores
La alternativa más utilizada para corregir defectos refractivos y adaptar la graduación según las necesidades visuales del paciente.
Lentes correctores
Ofrecen una visión más natural y un campo visual más amplio en comparación con los anteojos.
Cirugía refractiva
Procedimiento con láser que remodela la córnea mediante la creación de un flap corneal para corregir miopía, hipermetropía y astigmatismo.
Cirugía refractiva
Técnica con láser que no crea flap corneal. Puede ser útil en córneas delgadas o en casos en que LASIK no es la mejor opción.
Cirugía refractiva
Lentes implantadas dentro del ojo sin extraer el cristalino natural, indicadas en algunos pacientes con alta miopía, hipermetropía o astigmatismo.
Cristalino poco cataratoso
Reemplazo del cristalino por una lente intraocular para corregir presbicia en pacientes seleccionados. Se relaciona directamente con la cirugía de cataratas.
Corrección temporal
Uso nocturno de lentes especiales para modificar transitoriamente la curvatura corneal y reducir la miopía durante el día.

La cirugía refractiva corneal permite corregir defectos visuales modificando la forma de la córnea con láser Excimer o Femtoláser. Su objetivo es reducir y, en muchos casos, eliminar la necesidad de lentes ópticos.

Se crea una fina tapita o flap en la córnea, se aplica el láser corrector y luego se reposiciona el flap.
Ideal para: Pacientes que buscan una recuperación visual rápida.

Técnica superficial en la que el láser modifica directamente la córnea sin crear un flap.
Ideal para: Córneas más delgadas o pacientes con mayor riesgo de trauma ocular.

Se extrae un pequeño lentículo dentro de la córnea mediante una microincisión y láser femtosegundo.
Ideal para: Miopía y algunos pacientes con ojo seco leve.

El Centro Oftalmológico Láser de Santiago cuenta con equipamiento avanzado para cirugía corneal con láser, incluyendo tecnología Femtosegundo, láser Excimer y diagnóstico integrado.
Suite refractiva
Láser Femtosegundo de 200 kHz utilizado en tiempos quirúrgicos de cirugía láser y anillos corneales. Permite crear flaps finos y homogéneos, con baja energía y mejor preservación biomecánica.
Suite refractiva
Láser Excimer de alta velocidad, con seguimiento ocular multidimensional, ablación rápida y tecnologías orientadas a mantener la asfericidad corneal y la calidad visual nocturna.
Suite refractiva
Integra topografía, aberrometría y ray tracing para pasar de tratamientos estándar a tratamientos altamente personalizados según la óptica individual del ojo.

Las lentes intraoculares fáquicas se implantan dentro del ojo sin retirar el cristalino natural. Pueden ser una alternativa cuando el láser corneal no es la mejor opción.
La cirugía de cataratas consiste en extraer el cristalino opaco y reemplazarlo por una lente intraocular. Es una cirugía ambulatoria, habitualmente de un ojo por vez, y en la mayoría de los adultos se realiza con anestesia local.
La cirugía de cataratas tiene una tasa de éxito muy alta: más del 95% de los pacientes experimentan una mejoría significativa de la visión.

Esquema del polo anterior del ojo y del cristalino, la lente natural que pierde transparencia cuando aparece la catarata.
Monofocal, tórica, multifocal o EDOF no significan lo mismo. La selección requiere estudiar el astigmatismo, el estilo de vida, la lectura, el manejo nocturno y otras patologías oculares asociadas.
Tipo de lente intraocular (LIO)
Ofrecen un punto focal principal, habitualmente para visión lejana. Son las lentes más utilizadas y suelen requerir anteojos para lectura.
Tipo de lente intraocular (LIO)
Diseñadas para corregir astigmatismo durante la cirugía de cataratas. Pueden ser monofocales o multifocales.
Tipo de lente intraocular (LIO)
Permiten visión en distintas distancias y pueden reducir la dependencia de anteojos, aunque algunos pacientes pueden percibir halos o deslumbramientos.
Tipo de lente intraocular (LIO)
Ofrecen un rango extendido de foco con buena visión lejana e intermedia, y en algunos casos pueden requerir apoyo con anteojos de cerca.
El documento complementario profundiza en ojo seco como una causa muy habitual de molestias visuales. Su tratamiento depende del mecanismo predominante y de la intensidad de los síntomas.
El síndrome de ojo seco aparece cuando el ojo no produce suficientes lágrimas o cuando la película lagrimal pierde estabilidad y se evapora con rapidez.
Además de la cirugía refractiva y de cataratas, la consulta también considera patologías que pueden comprometer la visión de manera progresiva o incluso urgente.
Es un grupo de enfermedades que dañan el nervio óptico y pueden comprometer la visión de manera irreversible si no se detectan a tiempo.
Es una urgencia ocular en la que la retina se separa de su posición normal y necesita evaluación rápida para proteger la visión.
La mácula permite la visión central fina, la lectura y el reconocimiento de rostros, por lo que su compromiso puede alterar actividades cotidianas.
Es una complicación ocular de la diabetes mellitus, especialmente cuando existe mal control metabólico.
Algunos cuadros oftalmológicos pueden requerir atención pronta para evitar pérdida visual o daño permanente.
El material enviado también menciona motivos de consulta frecuentes que suelen requerir examen clínico, manejo médico, corrección óptica o derivación quirúrgica según el caso.
La evaluación permite estudiar alineación ocular, desarrollo visual y necesidad de manejo óptico, oclusión o derivación quirúrgica.
Incluye conjuntivitis agudas y crónicas, ojo seco, rosácea ocular, queratocono, queratitis, cuerpo extraño corneal, trauma ocular, causticaciones, pterigión, escleritis, epiescleritis, tumores benignos o malignos, chalazión y orzuelo.
Blefaritis, alteraciones palpebrales y molestias de superficie ocular también forman parte de la evaluación oftalmológica habitual.


El pterigión es una lesión conjuntival triangular que puede avanzar sobre la córnea, habitualmente desde el lado nasal. Debe diferenciarse de la pingüécula, que es frecuente y benigna.
Cuando está indicado, se retira la lesión bajo anestesia tópica y se reemplaza por un injerto de conjuntiva sana del mismo paciente, fijado con pegamento biológico o suturas.
La recurrencia actual es baja, aproximadamente del 5%, aunque depende de factores individuales y de la técnica.

Tumoración del cuerpo del párpado causada por obstrucción de una glándula de Meibomio. No corresponde a un absceso y no se relaciona directamente con el uso de cosméticos.
Cuando es molesto o muy crónico, puede drenarse con un procedimiento simple en pabellón.

Inflamación de un folículo piloso de una o más pestañas, ubicada en el margen del párpado. Es menos frecuente que el chalazión, pero más conocido.
Suele resolverse con calor local y masajes, aunque debe evaluarse si persiste, duele mucho o se repite.
Analiza la forma y curvatura de la córnea, detecta astigmatismo y enfermedades como el queratocono. El paciente solo debe mirar una luz durante algunos segundos.

La OCT de mácula permite diagnosticar y seguir enfermedades de la región central de la retina. La OCT de nervio óptico ayuda en glaucoma y otras neuropatías.

Mide el tamaño del ojo y permite calcular la potencia de la lente intraocular antes de una cirugía de cataratas.
Evalúa la calidad de la lágrima y las glándulas de Meibomio, siendo útil para diagnóstico avanzado del síndrome de ojo seco.

Mide resistencia y elasticidad de la córnea mediante un leve soplido de aire. Ayuda a detectar riesgo de ectasia y aporta información en glaucoma.

Evalúa la visión periférica mediante un campímetro. Es fundamental para diagnosticar y seguir glaucoma, alteraciones del nervio óptico y algunas enfermedades neurológicas.

Mide la presión ocular en distintos momentos del día para detectar variaciones que pueden pasar desapercibidas.

Estudia la circulación de la retina y puede detectar fugas, obstrucciones o daño vascular en retinopatía diabética, mácula o trombosis retinal.

Analiza las células internas de la córnea, su cantidad y forma. Es importante antes de cataratas, lentes intraoculares y enfermedades corneales.

Utiliza ultrasonido para evaluar el interior del ojo cuando no es posible observar bien el fondo ocular, por ejemplo en cataratas densas.
Centro Oftalmológico 20/20 cuenta con una sucursal de CDO, Centro de Diagnóstico en Oftalmología, lo que permite realizar muchos exámenes a continuación de la consulta médica y ganar tiempo diagnóstico.
Ver CDOSi tienes dudas sobre cirugía refractiva, cataratas u otra patología ocular, la indicación debe basarse en examen ocular, antecedentes y expectativas visuales realistas.